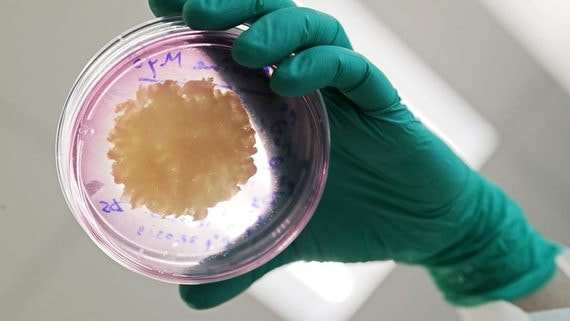
Продажи растительного мяса упали на 70%

Бизнес
Продажи растительного мяса упали на 70%
Потребители такой продукции или уехали из страны, или стали экономить

Читать полностью
на сайте www.vedomosti.ru
Потребители такой продукции или уехали из страны, или стали экономить